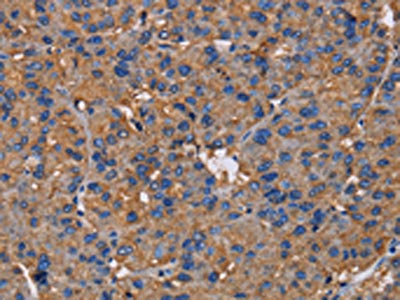

NCSTN Antibody
-
中文名稱:NCSTN兔多克隆抗體
-
貨號(hào):CSB-PA229917
-
規(guī)格:¥1100
-
圖片:
-
The image on the left is immunohistochemistry of paraffin-embedded Human liver cancer tissue using CSB-PA229917(NCSTN Antibody) at dilution 1/50, on the right is treated with fusion protein. (Original magnification: ×200)
-
The image on the left is immunohistochemistry of paraffin-embedded Human brain tissue using CSB-PA229917(NCSTN Antibody) at dilution 1/50, on the right is treated with fusion protein. (Original magnification: ×200)
-
-
其他:
產(chǎn)品詳情
-
Uniprot No.:
-
基因名:
-
別名:Anterior pharynx defective 2 antibody; APH 2 antibody; APH2 antibody; ATAG1874 antibody; KIAA0253 antibody; Ncstn antibody; NCT antibody; NICA_HUMAN antibody; Nicastrin antibody; RP11 517F10.1 antibody; RP11517F101 antibody
-
宿主:Rabbit
-
反應(yīng)種屬:Human,Mouse,Rat
-
免疫原:Fusion protein of Human NCSTN
-
免疫原種屬:Homo sapiens (Human)
-
標(biāo)記方式:Non-conjugated
-
抗體亞型:IgG
-
純化方式:Antigen affinity purification
-
濃度:It differs from different batches. Please contact us to confirm it.
-
保存緩沖液:-20°C, pH7.4 PBS, 0.05% NaN3, 40% Glycerol
-
產(chǎn)品提供形式:Liquid
-
應(yīng)用范圍:ELISA,IHC
-
推薦稀釋比:
Application Recommended Dilution ELISA 1:2000-1:5000 IHC 1:50-1:200 -
Protocols:
-
儲(chǔ)存條件:Upon receipt, store at -20°C or -80°C. Avoid repeated freeze.
-
貨期:Basically, we can dispatch the products out in 1-3 working days after receiving your orders. Delivery time maybe differs from different purchasing way or location, please kindly consult your local distributors for specific delivery time.
-
用途:For Research Use Only. Not for use in diagnostic or therapeutic procedures.
相關(guān)產(chǎn)品
靶點(diǎn)詳情
-
功能:Essential subunit of the gamma-secretase complex, an endoprotease complex that catalyzes the intramembrane cleavage of integral membrane proteins such as Notch receptors and APP (amyloid-beta precursor protein). The gamma-secretase complex plays a role in Notch and Wnt signaling cascades and regulation of downstream processes via its role in processing key regulatory proteins, and by regulating cytosolic CTNNB1 levels.
-
基因功能參考文獻(xiàn):
- Identification of a novel deletion mutation in exon 4 of NCSTN, which may underlie the molecular pathogenesis in this Acne inversa family. PMID: 30030622
- A physical interaction between nicastrin (hNCT) and the gamma-secretase substrate amyloid beta-protein precursor (APPC100) confirmed the functionality of hNCT as a substrate recognizer. PMID: 28276527
- The results show no differences in the decreased levels of inflammatory factors between patients with and without NCSTN mutations. This result may indicate that NCSTN mutations have no direct effect on inflammatory cells in the process of cytokine production. PMID: 27639175
- The authors identified two nonsynonymous mutations in NCSTN in a white population, one of which had previously been described in African American and Chinese patients with HS. In addition, several intronic polymorphisms within the NCSTN were identified that were present at a significantly higher frequency in the HS population. PMID: 26879264
- The results lead the investigators to speculate that NCSTN may be one of the genes determining the clinical phenotype of follicular HS . PMID: 26522179
- Loss of function of nicastrin impacts on cell proliferation and differentiation-associated signalling pathways in a keratinocyte cell line. PMID: 26473517
- analysis of two novel mutations segregating with familial hidradenitis suppurativa (acne inversa) and acne conglobate in NCSTN PMID: 26663538
- Case Report: large Chinese family harboring novel NCSTN mutation associated with acne inversa. PMID: 26463457
- Nicastrin mutation is associated with schizophrenia. PMID: 27008863
- haploinsufficiency of the NCSTN gene caused by the nonsense mutation c.1258C>T (p.Q420X) contributes to the occurrence of hidradenitis suppurativa in this family. PMID: 26224166
- The "Lid" domain of nicastrin is not essential for regulating gamma-secretase activity. PMID: 26887941
- SNPs in Notch pathway genes may be predictors of cutaneous melanoma disease-specific survival. PMID: 25953768
- Tumor necrosis factor-alpha and interleukin-10 levels were elevated in acne inversa patients with nicastrin or presenilin enhancer mutation. PMID: 26067312
- A strategy focused on MAPT, APP, NCSTN and BACE1 to build blood classifiers for Alzheimer's disease. PMID: 25863267
- Akt1 phosphorylates NCT at Ser437, significantly reducing NCT stability. A phospho-deficient mutation in NCT at Ser437 stabilized its protein levels. PMID: 25996556
- atomic structure of human gamma-secretase at 3.4 A resolution, determined by single-particle cryo-electron microscopy PMID: 26280335
- We suggest that this is the first description of an NCSTN nonsense mutation causing autosomal dominant hidradenitis suppurativa in an African American family. PMID: 25693063
- analysis of how the conformation of presenilin, Pen-2, Aph-1, and nicastrin affect the function and mechanism of gamma-secretase PMID: 25918421
- High nicastrin expression is associated with invasive breast cancer. PMID: 25248409
- Analysis of nicastrin structure provides insights into the assembly and architecture of the gamma-secretase complex. PMID: 25197054
- This paper demonstrated that Nicastrin and Notch4 are key molecules involved in resistance to endocrine therapy. The data suggest that targeting Notch4 and Nicastrin is a potential approach to reverse endocrine resistance in breast cancer patients. PMID: 24919951
- OCIAD2 also increased the interaction of nicastrin with C99 and stimulated APP processing via gamma-secretase activation, but did not affect Notch processing PMID: 24270855
- Two heterozygous missense mutations, c.647A>C (p.Q216P) in the exon 6, and c.223G>A (p.V75I) in the exon 3 of the NCSTN gene, were identified in the two families PMID: 22759192
- wild-type human nicastrin overexpression in transgenic mice promoted active assembly of the gamma-secretase complex through modulation of APP processing and behavior. PMID: 23595812
- Sequencing results showed that a heterozygous single nucleotide mutation c.1258C>T in exon 11 of NCSTN PMID: 23517242
- Generation of amyloid-beta is reduced by the interaction of calreticulin with amyloid precursor protein, presenilin and nicastrin. PMID: 23585889
- A review of mutations in the gamma-secretase genes NCSTN, PSENEN, and PSEN1 and the role of gamma-secretase in cutaneous biology and, more specifically in hidradenitis suppurativa. PMID: 23096707
- Results show that a splice site mutation in NCSTN protein, a gene encoding gamma secretase is implicated in the pathogenesis of hidradenitis suppurativa PMID: 22834455
- Mutations in the gamma-secretase genes NCSTN, PSENEN, and PSEN1 underlie rare forms of hidradenitis suppurativa (acne inversa). PMID: 22622421
- Finding suggest the development of nicastrin-targeted therapies in breast cancer. PMID: 23012411
- The gamma-secretase substrate receptor, nicastrin, was found to be modified by 4-hydroxynonenal in cultured neurons and in brain specimens from patients with Alzheimer's disease. PMID: 22404891
- Nicastrin is an essential component in the activation of gama-selectase complex. Its physical function and molecular genetic studies have been reveiwed. PMID: 22787765
- We therefore conclude that it is unlikely that common variation at the NCSTN locus is a risk factor for Alzheimer's disease. PMID: 22405046
- SGK1 is a gamma-secretase regulator presumably effective through phosphorylation and degradation of NCT. PMID: 22590650
- Data suggest that nicastrin functions as a "substrate receptor" within the gamma-secretase complex. PMID: 22586122
- We found three new mutations in nicastrin in hidradenitis suppurativa in French families. PMID: 22358060
- Data suggest that nicastrin (NCT) is a molecular target for the mechanism-based inhibition of gamma-secretase. PMID: 21725355
- Down-regulation of the ATP-binding cassette transporter 2 (Abca2) reduces amyloid-beta production by altering Nicastrin maturation and intracellular localization. PMID: 22086926
- The Nicastrin ectodomain has an exceptionally high propensity to refold after thermal denaturation. PMID: 21848507
- The pathogenic nature of these two mutations provides further evidence that the NCSTN gene is the disease gene of acne inversa PMID: 21495993
- confirmed the gene NCSTN is responsible for acne inversa by combining exome sequencing with previous genome-wide linkage analysis PMID: 21430701
- Deep sequencing of the Nicastrin gene in pooled DNA, the identification of genetic variants that affect risk of Alzheimer's disease. PMID: 21364883
- NCSTN and PSENEN, are involved in the pathogenesis of some familial hidradenitis suppurativa (Acne Inversa). PMID: 21412258
- Nicastrin can function to maintain epithelial to mesenchymal transition during breast cancer progression. PMID: 20224929
- study found independent loss-of-function mutations in PSENEN, PSEN1, or NCSTN in 6 Chinese acne inversa (AI) families; results identify the gamma-secretase component genes as culprits for a subset of familial AI PMID: 20929727
- Reduction in amyloid deposits is found in the forebrain of transgenic mice expressing S-palmitoylation-deficient nicastrin. PMID: 21123562
- Results indicate that the rs10752637 single-nucleotide polymorphism can likely influence the expression of nicastrin, and that this may be an influencing factor during the pathogenesis of Alzheimer's disease. PMID: 19840113
- nicastrin does not display aminopeptidase M- and B-like activities PMID: 11726200
- cell surface accumulation caused by presenilin 1 PMID: 11943765
- The gene encoding nicastrin, a major gamma-secretase component, modifies risk for familial early-onset Alzheimer disease in a Dutch population-based sample PMID: 11992262
顯示更多
收起更多
-
相關(guān)疾病:Acne inversa, familial, 1 (ACNINV1)
-
亞細(xì)胞定位:Membrane; Single-pass type I membrane protein. Cytoplasmic vesicle membrane; Single-pass type I membrane protein. Melanosome. Note=Identified by mass spectrometry in melanosome fractions from stage I to stage IV.
-
蛋白家族:Nicastrin family
-
組織特異性:Detected in brain (at protein level). Widely expressed.
-
數(shù)據(jù)庫鏈接:
Most popular with customers
-
-
YWHAB Recombinant Monoclonal Antibody
Applications: ELISA, WB, IHC, IF, FC
Species Reactivity: Human, Mouse, Rat
-
Phospho-YAP1 (S127) Recombinant Monoclonal Antibody
Applications: ELISA, WB, IHC
Species Reactivity: Human
-
-
-
-
-